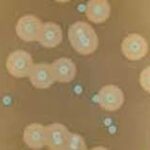

Las pruebas clínicas en personas por voluntad
propia los productos Regal Skin Lux muestran que:
– Reduce significativamente las arrugas en las
“patas de gallo”, que son las más profundas y las más difíciles en las que puede
influir un producto de belleza.
– Reduce las arrugas existentes en un 26%
– Estimula eficazmente la regeneración del tejido
conectivo dérmico y de ese modo promueve la densidad de la piel.
Crema regeneradora para una
hidratación intensa con células madre vegetales de argán para todo tipo de piel 30 +
Ayuda a prevenir y retrasar la
aparición de arrugas y alisado de las ya existentes. Crema innovadora y activadora
con PhytoCellTec Argán, células madre de Argán .Revitaliza las células madre de
la piel para mejorar la densidad de la piel. Las células madre de la piel
son aquellas que desempeñan un papel
crucial en la preservación de su juventud. La crema contribuye a la mejora de
la capacidad de regeneración de las células madre dérmicas, y como resultado, lograr
el rejuvenecimiento. Proporciona una intensa hidratación y nutrición a través de los aceites de nuez
de macadamia, almendra y jojoba. La alta concentración de agregado de ácido
hialurónico en la piel la hidrata en profundidad y retiene la humedad durante
más tiempo.
El Pack que compone el
tratamiento se compone de la mascarilla de noche con células de argán para todo
tipo de piel. Leche Limpiadora con aceite de argán. Crema regeneradora con
argán, hidratación intensiva. Crema regeneradora nutritiva con argán .Crema
regeneradora argán contorno de ojos y el serum rejuvenecedor con aceite de
argán , todos ellos para cualquier tipo de piel 30+ Regal Skin Lux.